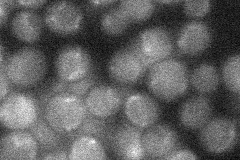
YPR191W
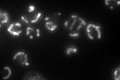
YPR191W

View description
Subunit 2 of the ubiquinol cytochrome-c reductase complex, which is a component of the mitochondrial inner membrane electron transport chain; phosphorylated; transcription is regulated by Hap1p, Hap2p/Hap3p, and heme
Localization:
Intensity:
Fold change:
Significance:
-
C’ GFP library in SD

mitochondria126.63 -
N' NOP1pr-GFP in SD

mitochondria128.171 -
N' TEF2pr-mCherry in SD

missing0 -
N' NATIVEpr-GFP in SD
below threshold19.1302 -
N' TEF2pr-VC and Cyto-VN in SD

#N/A0 -
C’ GFP library in SD+DTT

mitochondria161.81.27No -
C’ GFP library in SD+H2O2

mitochondria127.281No -
C’ GFP library in Starvation Media
mitochondria197.971.56Yes -
C’ GFP library on the background of Pup2-DaMP

mitochondria -
C’ GFP library on the background of CCT mutant

mitochondria118.5960.936514No
